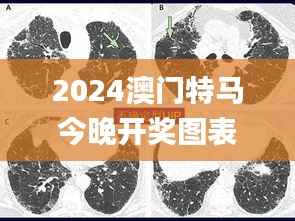
2024澳门特马今晚开奖图表,动态词汇解析_CT8.980

步入2024年,澳门特别行政区作为中西方文化交融的特区,不仅在经济上扮演着重要的角色,在彩票行业同样也有着不可忽视的地位。澳门特马(澳门特别行政区赛马)作为彩票领域的一大亮点,吸引了众多居民和游客的关注,尤其是新一代购彩者。而在今晚开奖的重要时刻,对于许多购彩者来讲,关注2024澳门特马开奖图表成为了不可或缺的购彩指南。在这样的背景下,本文将通过动态词汇解析的方式为读者带来详尽的购彩指导,以助您更好地参与到这场购彩盛宴中来。
---澳门特马简介
澳门特别行政区的赛马彩票行业历史悠久,拥有广泛的群众基础。特马,作为澳门最具影响力的赛事之一,每年都会吸引大量的观众与参与者。澳门特马包含了丰富的赛事信息,比如参赛马匹的数量、马力情况、骑手信息等,这些信息都会影响到赛马的结果。因此,购彩者需要密切关注这些信息,以便准确投注。同时,澳门特马还有着光荣的传统和丰厚的奖金,使得每次赛事都充满了期待和激情。
---澳门特馬今晚开奖图表重要性
对于购彩者来说,澳门特馬今晚开奖图表的了解至关重要。由于数据显示,了解详细的开奖图表能够让购彩者更加准确地掌握赛事走势,从而增加中奖的概率。此外,澳门特馬开奖图表还能帮助购彩者分析历史数据,增加对当前赛事赛况的预判力。以下是一些动态词汇解析的内容,旨在使您对澳门特馬有更深的认识。
---动态词汇解析_CT8.980
“CT8.980” 不仅是本次2024澳门特馬开奖图表的一个重要数字,还代表了一项独特的动态分析技术。该术语代表澳门特馬的数据分析系统的最新版本,即第8代,版本号为0.980,它能帮助购彩者获得及时、准确的赛马数据分析和预测。
CT代表动态跟踪技术(Continuous Tracking Technology),8.980则是系统版本。该技术可以实时追踪和分析参赛马匹的各项数据,如速度、耐力、健康状态等,进而提供即时更新的赛事分析报告。因此,对于购彩者而言,这种技术的运用不仅能提高他们策略性投注的能力,同时也能在一定程度上提高中奖概率。
---动态词汇解析十大要点
了解“CT8.980”系统的基本词汇,能让购彩者在澳门特馬投注时有的放矢,以下是十大要点的详细解析:
1. 赛事时间表: 购彩者需要知道每场赛事的具体时间,以确保及时参与每场赛马。 2. 参赛马匹信息: 包括马匹的健康状况、赛事历史、速度等信息。 3. 骑手履历: 骑手的经验也是决定胜负的重要因素,了解骑手的表现历史对其成绩预测至关重要。 4. 赛道状况: 不同天气状况和赛道条件对马匹的表现有显著影响,这部分信息需要随时关注。 5. 赔率变动: 赔率是购彩者参考投注的重要信息之一,实时关注赔率波动有利于选择最佳投注时机。 6. 历史数据分析: 通过CT8.980系统,购彩者可以获得每匹马历史赛绩的回溯分析,辅助作出决策。 7. 天气预测: 天气对赛马有重大影响,了解当天的天气预报能帮助购彩者更好地预测赛事结果。 8. 投注策略: 根据澳门特馬的赛马信息和赔率变化,制定出科学的投注策略。 9. 报销率: 了解报销率可以帮助购彩者计算自己的投注成本和潜在收益。 10. 风控管理: 负责任的购彩还涉及到对投注风险的管理,保证在享受比赛带来的快乐的同时,规避不必要的财务风险。
---如何使用CT8.980动态词汇分析
澳门特马的购彩攻略不仅仅依赖直觉,更多时候是依赖于精准的数据分析。CT8.980为购彩者提供了先进的数据分析系统,如何充分利用这项技术至关重要。
1. 利用CT8.980系统 追踪 每场赛事的动态信息,包括马匹的实时动态和赛马场的变化。 2. 随时关注CT8.980系统提供的 赔率 和 赛道条件,配合自身经验进行投注。 3. 参考CT8.980提供的历史赛马数据,进行 统计分析 和 概率推演。 4. 结合自身情况制定 投注计划,同时也参考CT8.980系统给出的 趋势预测。 5. 在赛事结束后,通过CT8.980系统总结赛事结果, 调整 投注策略,以便下一次更加精准投注。
---总结
2024澳门特馬作为区域性的赛马彩票盛事,不仅为购彩者提供了娱乐和收益的机会,同时也促进了地区经济发展。通过本文的动态词汇解析,您已了解到查看今晚开奖图表的重要性以及如何运用CT8.980的数据分析技术。希望您能带着深入的认识和理解,自信地参与到澳门特馬的购彩活动当中,享受比赛带来的刺激和乐趣。
转载请注明来自深圳市鹏腾电子发展有限公司,本文标题:《2024澳门特马今晚开奖图表,动态词汇解析_CT8.980》

粤ICP备19130523号-1
粤ICP备19130523号-1
还没有评论,来说两句吧...